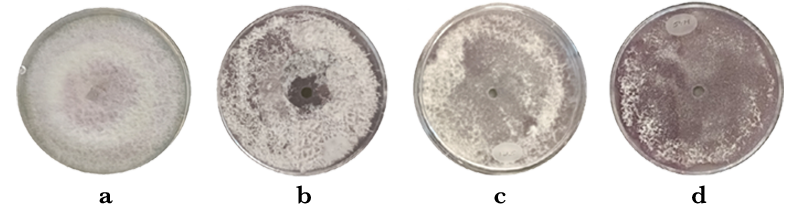

La sinergia de nanomateriales como nuevos fungicidas
Iliana C. Ruiz-Leyva1, Luis A. Hermida-Montero1, Francisco Paraguay-Delgado1, Nicolaza Pariona-Mendoza2, Laila N. Muñoz-Castellano3

La combinación de nanopartículas metálicas y quitosano con propiedades antifúngicas podría ser una nueva opción para el control de hongos que afectan a los cultivos.
Palabras claves: nanotecnología, hongos, fungicidas.
Estamos familiarizados con hongos visibles como los champiñones comestibles y setas silvestres. Sin embargo, una gran proporción de hongos son de tamaño microscópico; es decir, necesitamos de un microscopio para identificarlos. A pesar de que estos hongos no son observables a simple vista, somos testigos de ellos a través de frutos y vegetales en descomposición. Estos alimentos, tras un largo tiempo de almacenamiento, adquieren manchas en tonalidades negras o cafés, los cuales son evidencia de crecimiento de hongos. En la agricultura, los hongos que atacan a los diversos cultivos son denominados hongos fitopatógenos y son causantes de enormes pérdidas monetarias en las producciones agrícolas alrededor del mundo. Particularmente, el hongo del género Fusarium causa marchitez vascular en las plantas. Este hongo es cosmopolita y ocupa el quinto lugar en una lista de los 10 principales hongos fitopatógenos de importancia científica y económica. Este hongo tiene la capacidad de infectar a más de 100 cultivos diferentes. Los síntomas que generan son la pudrición de raíz y frutos, marchitamiento en las hojas; y en consecuencia, la muerte de la planta [1].

Imágenes obtenidas con microscopio electrónico de transmisión de a) NPs de ZnO y b) ZnO-quitosano (Imágenes: Francisco Paraguay Delgado y Luis A. Hermida Montero)
Para contrarrestar la problemática de Fusarium, se usan productos químicos denominados fungicidas (por ejemplo, Prozycar, Manzate 200, Axotrón, Tibend, entre otros.), los cuales impiden la generación de esporas (semillas de hongos) evitando así la reproducción del hongo. Sin embargo, el uso constante de estos productos químicos ha generado un aumento en la contaminación ambiental y la resistencia de los hongos a estos fungicidas [2]. Una alternativa al uso de los fungicidas tradicionales está la aplicación de los nanomateriales o nanopartículas (NPs). Las nanopartículas son partículas sólidas cuyo tamaño está entre 1-100 nanómetros (nm); siendo un nm una millonésima parte de un metro, semejante a dividir un millón de veces un milímetro. Las nanopartículas, debido a su tamaño, tienen propiedades antimicrobianas superiores a aquellas partículas del mismo compuesto de mayor tamaño. Así mismo, la combinación de NPs de diferente composición química (ejemplo, zinc, cobre, etc.) con propiedades antimicrobianas similares puede generar una sinergia y ser más eficientes. Un ejemplo de sinergia es el uso de NPs de óxido de zinc (ZnO) recubiertas con quitosano, que a pesar de su diferente origen (químico y biológico, respectivamente), ambos tienen propiedades antifúngicas. Por lo tanto, la sinergia de estos dos compuestos podría potenciar los mecanismos antifúngicos y llevar a la muerte de hongos fitopatógenos.
Crecimiento del hongo de Fusarium oxysporum expuesto a diferentes tratamientos en una concentración de 1 mg/mL. a) sin tratamiento, b) quitosano, c) NPs de ZnO y d) NPs de ZnO-quitosano. (Imágenes: Iliana C. Ruiz Leyva)
En trabajos colaborativos entre CIMAV, UACH e INECOL se está investigando la preparación de NPs de ZnO puras y NPs ZnO en combinación con quitosano (ZnO-quitosano) (Figura 1) con propiedades antifúngicas para el control del hongo Fusarium oxysporum. A la fecha, se ha observado que los tamaños y formas de las NPs de ZnO cambian al combinar con el quitosano. Es decir, las NPs de ZnO puras son esferas con tamaño de 10 nm; mientras que, las NPs ZnO con quitosano tienen la forma de láminas y son de 70 nm. De igual manera, al evaluar la actividad antifúngica de las NPS de ZnO puras y el quitosano por separado, así como de ZnO-quitosano, se ha observado un comportamiento sinérgico de este último. El crecimiento del hongo disminuye un 30 % con el quitosano, 75 % con ZnO puro y 90 % con la sinergia de ZnO-quitosano (Figura 2). De tal manera, estos resultados demuestran el potencial de la sinergia de las NPs con otros componentes como alternativa de nuevos fungicidas para el control de diversos hongos fitopatógenos.
Referencias
- R. Dean et al., “The Top 10 fungal pathogens in molecular plant pathology,” Mol. Plant Pathol., vol. 13, no. 4, pp. 414–430, 2012, doi: 10.1111/j.1364-3703.2011.00783.x.
- M. C. Fisher, N. J. Hawkins, D. Sanglard, and S. J. Gurr, “Worldwide emergence of resistance to antifungal drugs challenges human health and food security,” Science, vol. 360, no. 6390, pp. 739–742, 2018, doi: 10.1126/science.aap7999.
1 Laboratorio Nacional de Nanotecnología, Centro de Investigación en Materiales Avanzados S.C. (CIMAV).
2 Red de Estudios Moleculares Avanzados, Instituto de Ecología A.C (INECOL).
3 Facultad de Ciencias Químicas, Universidad Autónoma de Chihuahua (UACH).